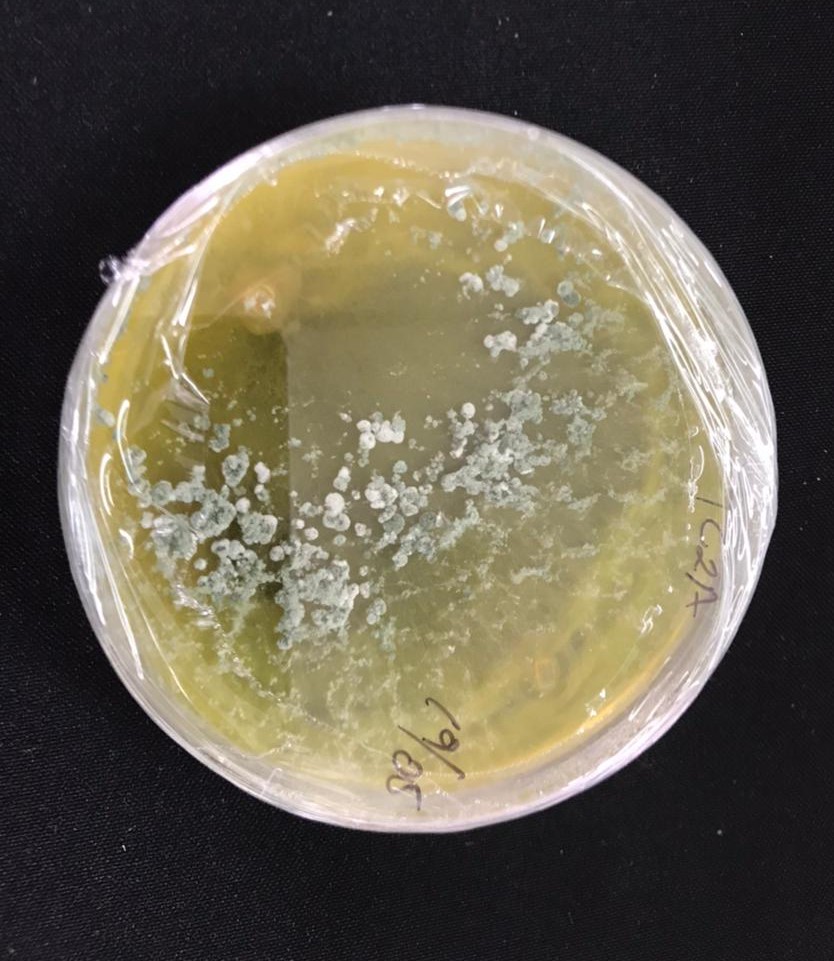

Pósters: Facultad de Ciencias Naturales y Matemáticas

Ingeniería Química
ESTUDIO DE LA VIDA ÚTIL DE ZUNCHOS PLÁSTICOS DE USO AGRÍCOLA E INDUSTRIAL MEDIANTE ANÁLISIS DE CORRELACIÓN APLICANDO LAS TÉCNICAS FTIR, DSC Y SEM.
Adriana Patricia Espinoza Cevallos, Nury Gabriela Mite Guzman

Ingeniería Química
Evaluación de un dispositivo para el muestreo de nitritos y material particulado presentes en el aire en sectores estratégicos de la ciudad de Guayaquil
Walther Jordan Arroyo Tenorio, Jorge Ricardo Velasquez Palma

Ingeniería Química
Evaluación de un sistema de recuperación de aguas ácidas en una planta de congelamiento de banano
Daniela Domenica Moreno Naranjo, Fabiola Sofya Gutierrez Rodriguez

Ingeniería Química
Evaluación del sistema de tratamiento anaeróbico de aguas residuales domésticas y su impacto en emisiones de gases de efecto invernadero a partir de ensayos de co-digestión anaerobia.
Monica Antonella Anguisaca Molina, Anthonela Salome Chinchin Martinez

Ingeniería Química
MODELO PARA EL PROCESO DE DESTILACIÓN POR CARGAS PARA LA SEPARACIÓN DE ACEITES ESENCIALES, EN UN SIMULADOR COMERCIAL EN ESTADO TRANSITORIO.
Jhon Abel Rios Sanchez, Ariana Eloisa Gonzalez De La Torre

Ingeniería Química
Optimización del proceso de fundición de aluminio para reducir los defectos en piezas artesanales mediante la sustitución de la arena de moldeo y la implementación de desgasificante en la colada
Diana Angelica Velastegui Nieve, Daniela Lisseth Hidalgo Enriquez
Ingeniería Química
Producción de bioetanol a partir de hidrólisis enzimática con Trichoderma ssp y posterior fermentación alcohólica con saccharomyses cerevisiae de cáscara de cacao
Fernanda Carolina Chacha Coyago, Viviana Andrea Corrales Mendoza

Ingeniería Química
Tratamiento de ácidos grasos con plasma frío de alto voltaje bajo condiciones de presión atmosférica para la síntesis de bio-productos
Ximena Elizabeth Orellana Jaramillo, Saddy Karina Pasquel Andrade

Matemática
Aproximación numérica de un modelo usado para la simulación de la transferencia de masa y calor en un secador de azúcar
Franklin Andres BolaÑos Flores, Frank Anthony Herrera Nolivos
- « primero
- ‹ anterior
- 1
- 2
- 3
- 4